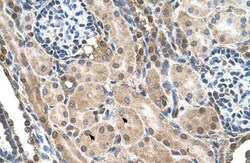

Promotional price valid on web orders only. Your contract pricing may differ. Interested in signing up for a dedicated account number?
Learn More
Learn More
TMEM231 Antibody, Novus Biologicals™


Rabbit Polyclonal Antibody
$487.50
Specifications
| Antigen | TMEM231 |
|---|---|
| Applications | Western Blot, Immunohistochemistry, Immunohistochemistry (Paraffin) |
| Classification | Polyclonal |
| Conjugate | Unconjugated |
| Form | Purified |
Description
TMEM231 Polyclonal specifically detects TMEM231 in Human samples. It is validated for Western Blot, Immunohistochemistry, Immunohistochemistry-Paraffin.Specifications
| TMEM231 | |
| Polyclonal | |
| Purified | |
| RUO | |
| ALYE870, FLJ22167, PRO1886, transmembrane protein 231 | |
| TMEM231 | |
| IgG | |
| Protein A purified |
| Western Blot, Immunohistochemistry, Immunohistochemistry (Paraffin) | |
| Unconjugated | |
| Rabbit | |
| Q9H6L2 | |
| 79583 | |
| Synthetic peptides corresponding to TMEM231. The peptide sequence was selected from the N terminal of TMEM231. Peptide sequence CHEAPRARSARAGLPNRLPTALFNSGFWLKRSSYEEQPTVRFQHQVLLVA. | |
| Primary |
Spot an opportunity for improvement?Share a Content Correction
Product Content Correction
Your input is important to us. Please complete this form to provide feedback related to the content on this product.
Product Title